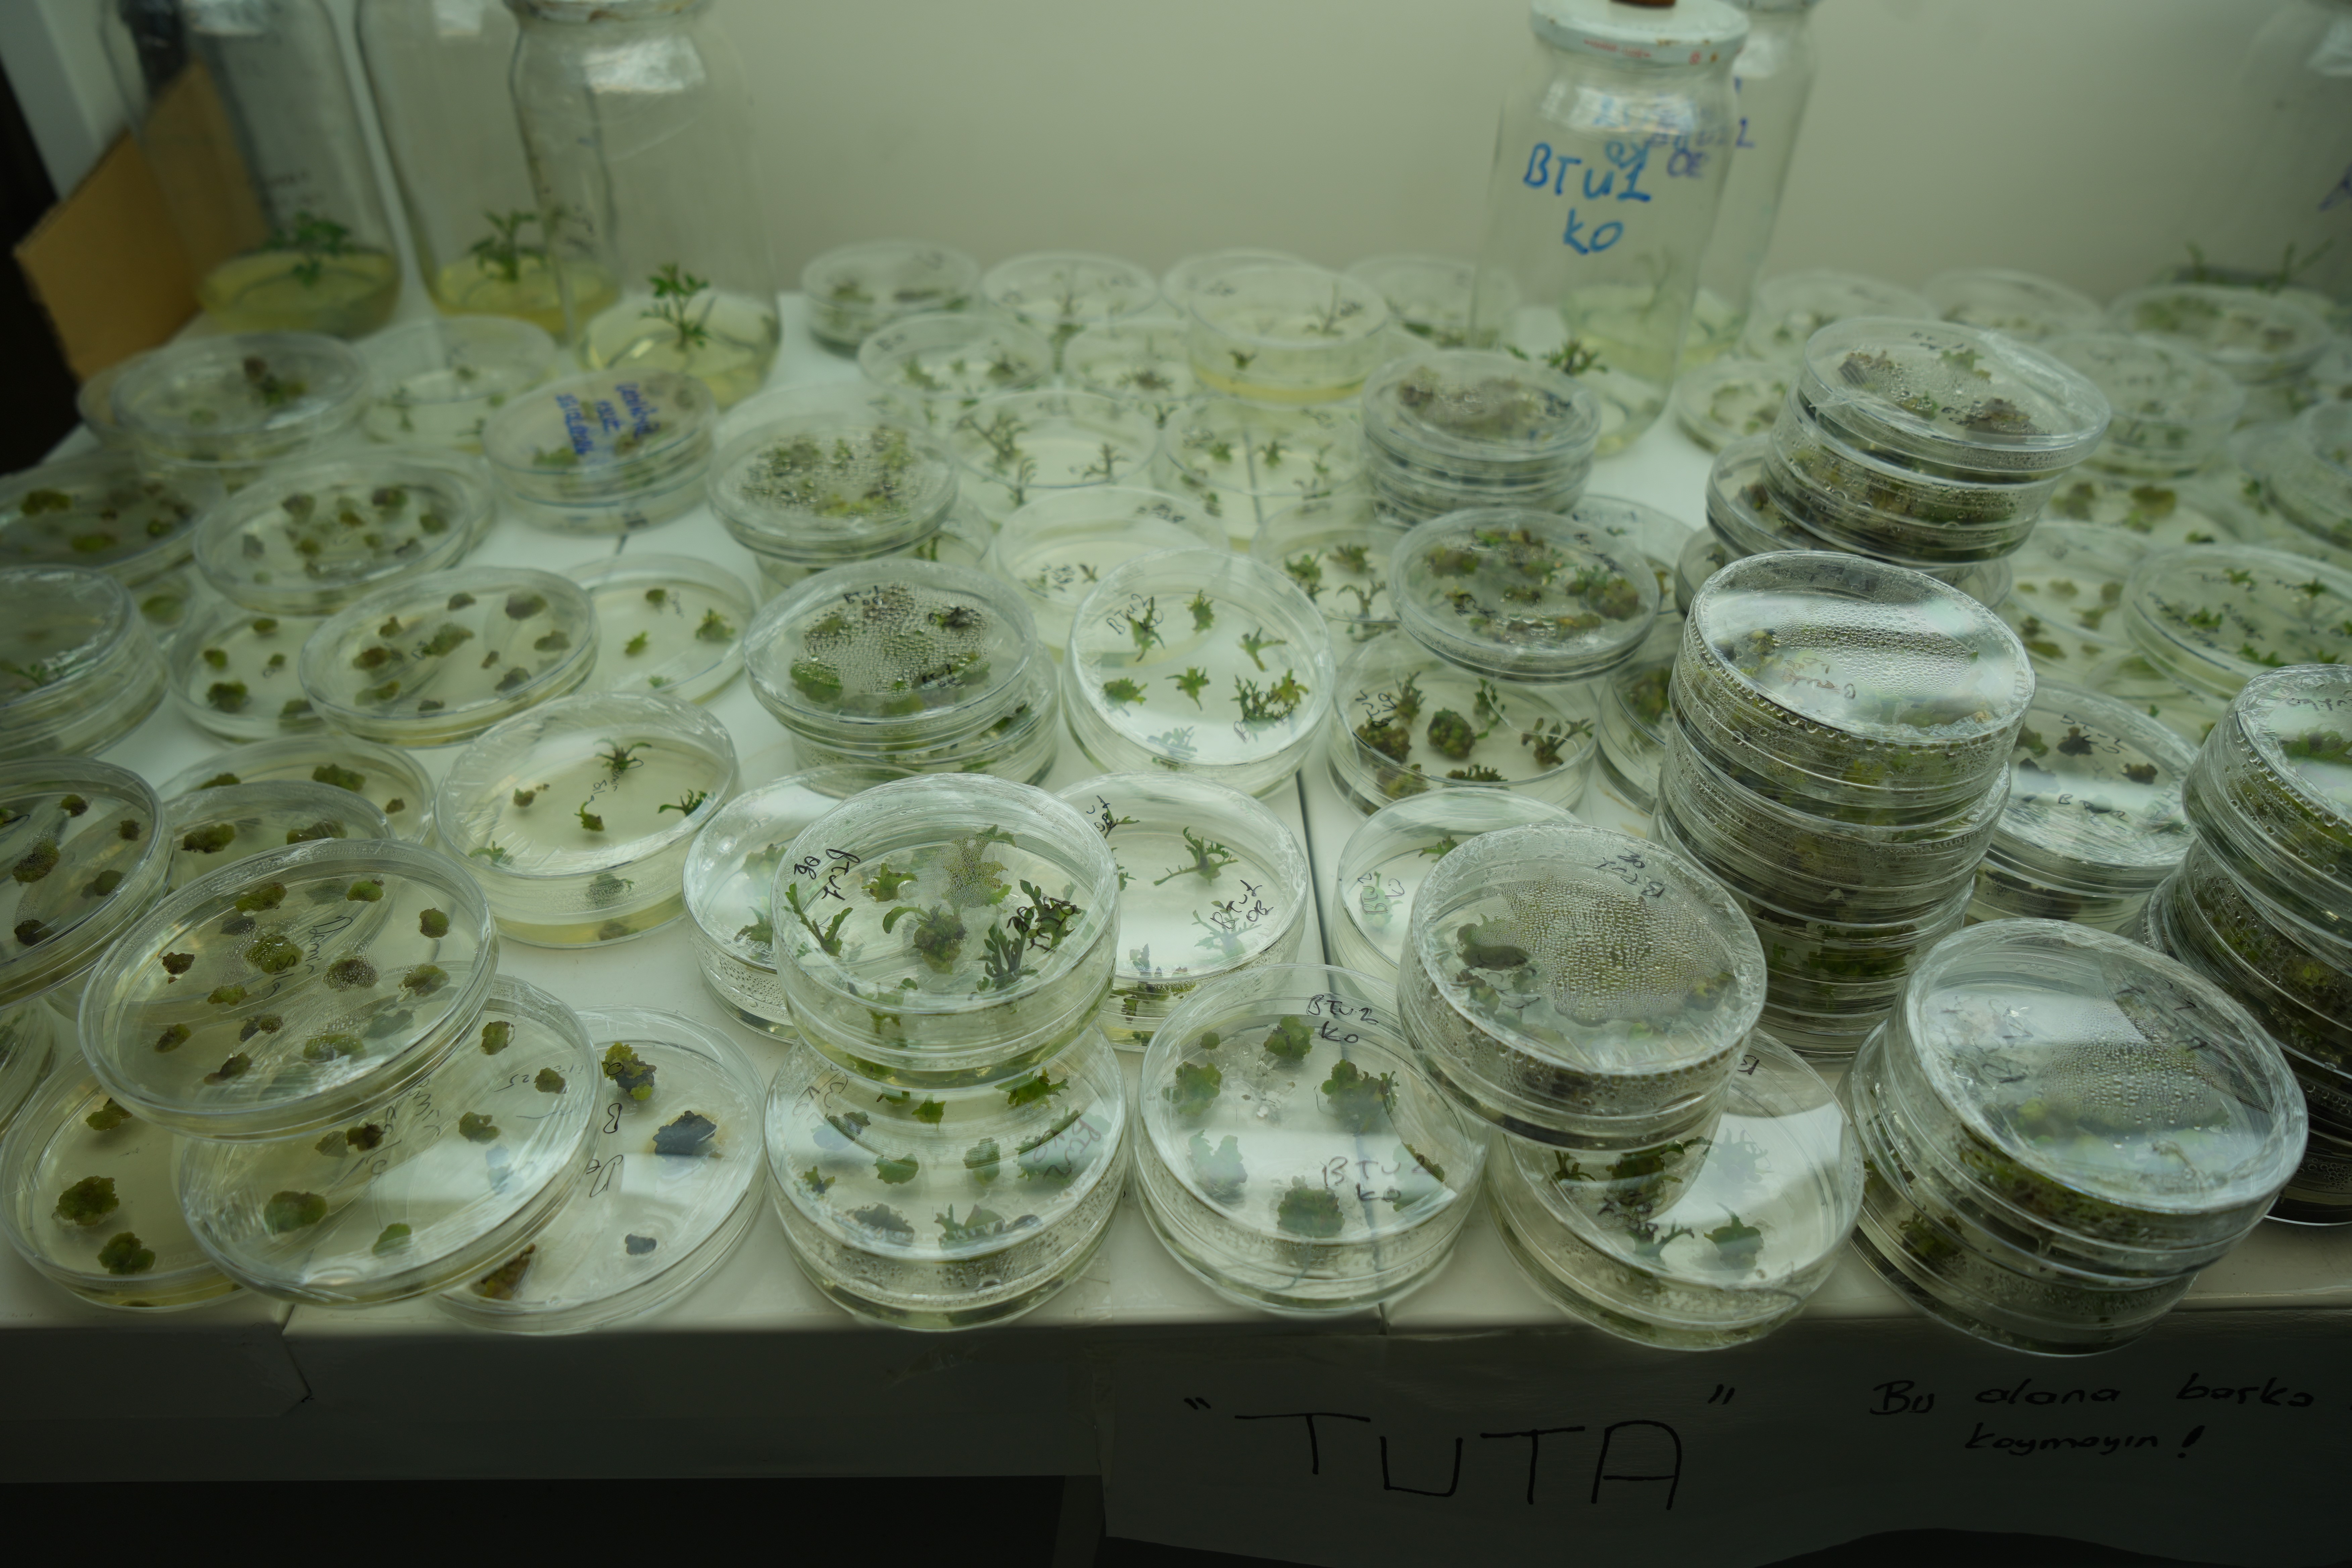

OMÜ Ziraat Fakültesi Tarımsal Biyoteknoloji Bölümü Öğr. Üyesi Prof. Dr. Musa Kavas danışmanlığında Biyoteknoloji Bölümü doktora öğrencisi Pakistanlı Momna Mehmood tarafından yürütülen araştırmada, iklim değişikliğinin tarım üzerindeki olumsuz etkilerine karşı çözüm üretilmesi amaçlanıyor. Özellikle su kaynaklarının azalmasıyla birlikte üretimi zorlaşan domates bitkisinin kuraklık karşısındaki dayanıklılık mekanizması mercek altına alındı.
Çalışma kapsamında daha önce geliştirilen ve gen düzenleme yöntemiyle elde edilen "J-03" isimli özel domates hattı inceleniyor. Araştırmada, bu domateslerin kuraklık altında hangi genleri devreye soktuğu, strese karşı nasıl tepki verdiği ve diğer bitkilere göre ne tür farklılıklar gösterdiği araştırılıyor. Proje, hem normal domates bitkilerini hem de gen düzenlemesi yapılmış hatları karşılaştırarak kuraklığa dayanıklılığı artıran biyolojik mekanizmaları ortaya koymayı hedefliyor. Laboratuvar analizleri ve bitkiler üzerinde yapılan ölçümlerle, kuraklık stresine karşı verilen tepkiler detaylı şekilde inceleniyor. Araştırma sonunda elde edilecek verilerin, gelecekte daha az suyla yetişebilen ve iklim değişikliğine karşı daha dirençli tarım ürünlerinin geliştirilmesine katkı sağlaması bekleniyor.

"Su kaybını azaltmaya yönelik düzenlemeler gerçekleştirmeyi hedefliyoruz"
Konuya ilişkin açıklamalarda bulunan Prof. Dr. Musa Kavas, domates üretiminde kuraklığın en önemli risklerden biri olduğunu belirtti. Kavas, "Domates üretimini etkileyen birçok faktör var. Bunlardan en önemlisi kuraklık. Son yıllarda küresel ısınmayla birlikte yağış rejiminde büyük değişiklikler meydana geldi. Ülkemizde de son yıllarda yağışların azalması nedeniyle bitkisel üretimde düşüşler yaşanıyor. Özellikle açık arazide domates üretimi yapıldığında, üretim büyük ölçüde yağışa bağımlı olduğu için kurak dönemlerde önemli verim kayıpları görülüyor. Domates her ne kadar sulanabilen bir bitki olsa da doğal yağışlara bağlılık gösterdiğinden, kuraklık üretim açısından en önemli faktörlerden biridir. Laboratuvarımızda şu anda genom düzenleme projeleri yürütüyoruz. Doktora öğrencimin çalışmasında, domateste var olan bazı genleri iyileştirmeye yönelik düzenlemeler yapıyoruz. CRISPR olarak adlandırılan genom düzenleme tekniğini kullanıyoruz. Buradaki temel amacımız, domatesin suyu daha verimli kullanabilmesini ve topraktan daha fazla su alabilmesini sağlamak. Bu doğrultuda hem kök yapısında değişiklikler yapmayı hem de yapraklardan su kaybını azaltmaya yönelik düzenlemeler gerçekleştirmeyi hedefliyoruz. Daha önce yaptığımız bazı çalışmalarda başarılı sonuçlar elde ettik. Farklı genlerde yaptığımız değişikliklerle özellikle kök sayısının artırılmasının domatesi kuraklığa daha dayanıklı hale getirdiğini gördük. Ana hedefimiz, strese maruz kalsa bile tolerans gösterebilen ve üretimde düşüş yaşanmayan bir domates geliştirmek" dedi.
Doktora öğrencimin çalışmasında, domateste var olan bazı genleri iyileştirmeye yönelik düzenlemeler yapıyoruz. CRISPR olarak adlandırılan genom düzenleme tekniğini kullanıyoruz. Buradaki temel amacımız, domatesin suyu daha verimli kullanabilmesini ve topraktan daha fazla su alabilmesini sağlamak. Bu doğrultuda hem kök yapısında değişiklikler yapmayı hem de yapraklardan su kaybını azaltmaya yönelik düzenlemeler gerçekleştirmeyi hedefliyoruz. Daha önce yaptığımız bazı çalışmalarda başarılı sonuçlar elde ettik. Farklı genlerde yaptığımız değişikliklerle özellikle kök sayısının artırılmasının domatesi kuraklığa daha dayanıklı hale getirdiğini gördük. Ana hedefimiz, strese maruz kalsa bile tolerans gösterebilen ve üretimde düşüş yaşanmayan bir domates geliştirmek" dedi.
Araştırmayı yapan Pakistanlı OMÜ doktora öğrencisi Momna Mehmood, "Bu proje başarılı olursa domateste çok yeni bir şey olacak. Literatür için çok önemli bir katkı sağlayacak" diye konuştu.
Çalışma kapsamında daha önce geliştirilen ve gen düzenleme yöntemiyle elde edilen "J-03" isimli özel domates hattı inceleniyor. Araştırmada, bu domateslerin kuraklık altında hangi genleri devreye soktuğu, strese karşı nasıl tepki verdiği ve diğer bitkilere göre ne tür farklılıklar gösterdiği araştırılıyor. Proje, hem normal domates bitkilerini hem de gen düzenlemesi yapılmış hatları karşılaştırarak kuraklığa dayanıklılığı artıran biyolojik mekanizmaları ortaya koymayı hedefliyor. Laboratuvar analizleri ve bitkiler üzerinde yapılan ölçümlerle, kuraklık stresine karşı verilen tepkiler detaylı şekilde inceleniyor. Araştırma sonunda elde edilecek verilerin, gelecekte daha az suyla yetişebilen ve iklim değişikliğine karşı daha dirençli tarım ürünlerinin geliştirilmesine katkı sağlaması bekleniyor.

"Su kaybını azaltmaya yönelik düzenlemeler gerçekleştirmeyi hedefliyoruz"
Konuya ilişkin açıklamalarda bulunan Prof. Dr. Musa Kavas, domates üretiminde kuraklığın en önemli risklerden biri olduğunu belirtti. Kavas, "Domates üretimini etkileyen birçok faktör var. Bunlardan en önemlisi kuraklık. Son yıllarda küresel ısınmayla birlikte yağış rejiminde büyük değişiklikler meydana geldi. Ülkemizde de son yıllarda yağışların azalması nedeniyle bitkisel üretimde düşüşler yaşanıyor. Özellikle açık arazide domates üretimi yapıldığında, üretim büyük ölçüde yağışa bağımlı olduğu için kurak dönemlerde önemli verim kayıpları görülüyor. Domates her ne kadar sulanabilen bir bitki olsa da doğal yağışlara bağlılık gösterdiğinden, kuraklık üretim açısından en önemli faktörlerden biridir. Laboratuvarımızda şu anda genom düzenleme projeleri yürütüyoruz.
Doktora öğrencimin çalışmasında, domateste var olan bazı genleri iyileştirmeye yönelik düzenlemeler yapıyoruz. CRISPR olarak adlandırılan genom düzenleme tekniğini kullanıyoruz. Buradaki temel amacımız, domatesin suyu daha verimli kullanabilmesini ve topraktan daha fazla su alabilmesini sağlamak. Bu doğrultuda hem kök yapısında değişiklikler yapmayı hem de yapraklardan su kaybını azaltmaya yönelik düzenlemeler gerçekleştirmeyi hedefliyoruz. Daha önce yaptığımız bazı çalışmalarda başarılı sonuçlar elde ettik. Farklı genlerde yaptığımız değişikliklerle özellikle kök sayısının artırılmasının domatesi kuraklığa daha dayanıklı hale getirdiğini gördük. Ana hedefimiz, strese maruz kalsa bile tolerans gösterebilen ve üretimde düşüş yaşanmayan bir domates geliştirmek" dedi.
Doktora öğrencimin çalışmasında, domateste var olan bazı genleri iyileştirmeye yönelik düzenlemeler yapıyoruz. CRISPR olarak adlandırılan genom düzenleme tekniğini kullanıyoruz. Buradaki temel amacımız, domatesin suyu daha verimli kullanabilmesini ve topraktan daha fazla su alabilmesini sağlamak. Bu doğrultuda hem kök yapısında değişiklikler yapmayı hem de yapraklardan su kaybını azaltmaya yönelik düzenlemeler gerçekleştirmeyi hedefliyoruz. Daha önce yaptığımız bazı çalışmalarda başarılı sonuçlar elde ettik. Farklı genlerde yaptığımız değişikliklerle özellikle kök sayısının artırılmasının domatesi kuraklığa daha dayanıklı hale getirdiğini gördük. Ana hedefimiz, strese maruz kalsa bile tolerans gösterebilen ve üretimde düşüş yaşanmayan bir domates geliştirmek" dedi.Araştırmayı yapan Pakistanlı OMÜ doktora öğrencisi Momna Mehmood, "Bu proje başarılı olursa domateste çok yeni bir şey olacak. Literatür için çok önemli bir katkı sağlayacak" diye konuştu.










